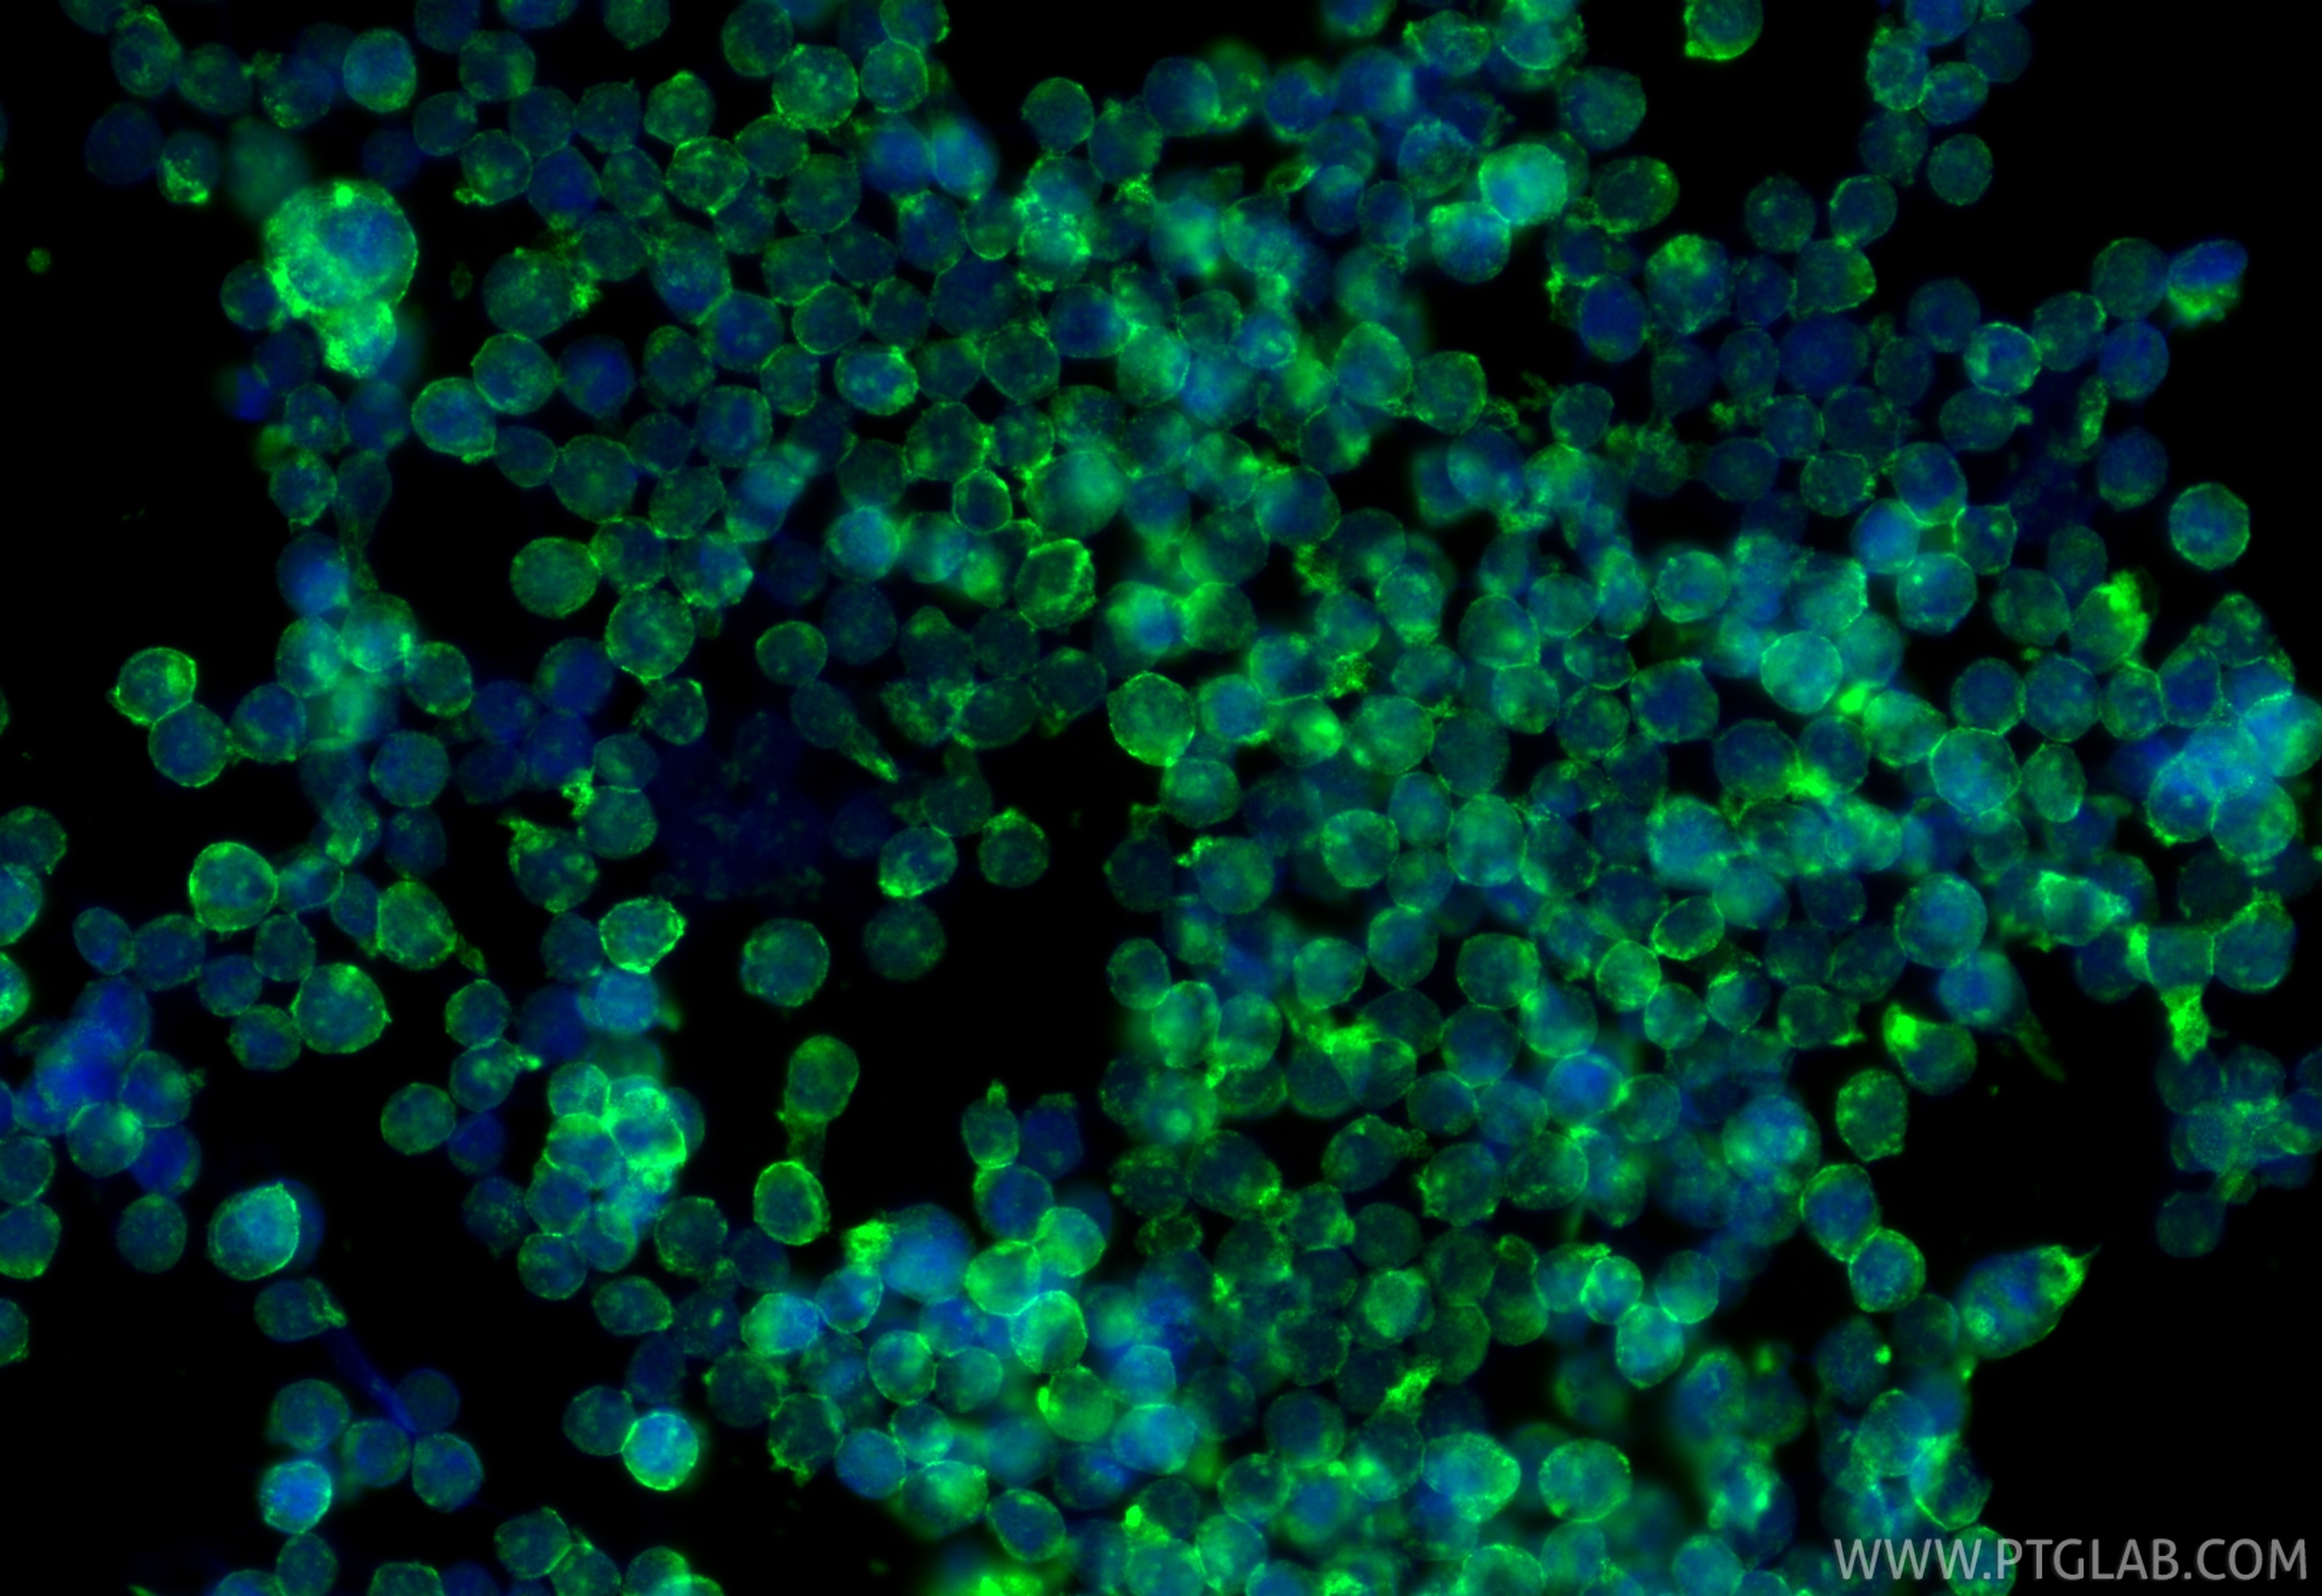
Immunofluorescence (IF) / fluorescent staining of THP-1 cells using CXCR2 Polyclonal antibody (20634-1-AP)

Validation Data Gallery
Tested Applications
| Positive WB detected in | L02 cells, COLO 320 cells |
| Positive IP detected in | HepG2 cells |
| Positive IHC detected in | human tonsillitis tissue Note: suggested antigen retrieval with TE buffer pH 9.0; (*) Alternatively, antigen retrieval may be performed with citrate buffer pH 6.0 |
| Positive IF-P detected in | mouse liver tissue |
Recommended dilution
| Application | Dilution |
|---|---|
| Western Blot (WB) | WB : 1:1000-1:4000 |
| Immunoprecipitation (IP) | IP : 0.5-4.0 ug for 1.0-3.0 mg of total protein lysate |
| Immunohistochemistry (IHC) | IHC : 1:50-1:500 |
| Immunofluorescence (IF)-P | IF-P : 1:50-1:500 |
| It is recommended that this reagent should be titrated in each testing system to obtain optimal results. | |
| Sample-dependent, Check data in validation data gallery. | |
Published Applications
| KD/KO | See 2 publications below |
| WB | See 21 publications below |
| IHC | See 7 publications below |
| IF | See 15 publications below |
| CoIP | See 2 publications below |
Product Information
20634-1-AP targets CXCR2 in WB, IHC, IF-P, IP, CoIP, ELISA applications and shows reactivity with human samples.
| Tested Reactivity | human |
| Cited Reactivity | human, mouse, rat |
| Host / Isotype | Rabbit / IgG |
| Class | Polyclonal |
| Type | Antibody |
| Immunogen |
CatNo: Ag14670 Product name: Recombinant human IL-8RB/CXCR2 protein Source: e coli.-derived, PGEX-4T Tag: GST Domain: 1-57 aa of BC037961 Sequence: MEDFNMESDSFEDFWKGEDLSNYSYSSTLPPFLLDAAPCEPESLEINKYFVVIIYAL 相同性解析による交差性が予測される生物種 |
| Full Name | interleukin 8 receptor, beta |
| Calculated molecular weight | 360 aa, 41 kDa |
| Observed molecular weight | 45-50 kDa |
| GenBank accession number | BC037961 |
| Gene Symbol | IL8RB |
| Gene ID (NCBI) | 3579 |
| RRID | AB_10693624 |
| Conjugate | Unconjugated |
| Form | |
| Form | Liquid |
| Purification Method | Antigen affinity purification |
| UNIPROT ID | P25025 |
| Storage Buffer | PBS with 0.02% sodium azide and 50% glycerol{{ptg:BufferTemp}}7.3 |
| Storage Conditions | Store at -20°C. Stable for one year after shipment. Aliquoting is unnecessary for -20oC storage. |
Background Information
IL8RB, also named as CXCR2, GRO/MGSA receptor, IL-8 receptor type 2, CDw128b, and CD182, belongs to the G-protein coupled receptor 1 family. It is a receptor for interleukin-8 which is a powerful neutrophil chemotactic factor. The binding of IL-8 to the receptor causes activation of neutrophils. This response is mediated via a G-protein that activates a phosphatidylinositol-calcium second messenger system. It binds to IL-8 with high affinity. IL8RB also binds with high affinity to CXCL3, GRO/MGSA, and NAP-2.
Protocols
| Product Specific Protocols | |
|---|---|
| IF protocol for CXCR2 antibody 20634-1-AP | Download protocol |
| IHC protocol for CXCR2 antibody 20634-1-AP | Download protocol |
| IP protocol for CXCR2 antibody 20634-1-AP | Download protocol |
| WB protocol for CXCR2 antibody 20634-1-AP | Download protocol |
| Standard Protocols | |
|---|---|
| Click here to view our Standard Protocols |
Publications
| Species | Application | Title |
|---|---|---|
Sci Adv An annular corneal microneedle patch for minimally invasive ophthalmic drug delivery | ||
EMBO Mol Med Targeting HPK1 inhibits neutrophil responses to mitigate post-stroke lung and cerebral injuries | ||
Mater Today Bio A biomimetic multimodal nanoplatform combining neutrophil-coated two-dimensional metalloporphyrinic framework nanosheet and exendin-4 to treat obesity-related osteoporosis | ||
Cell Death Dis Pivotal role of IL-8 derived from the interaction between osteosarcoma and tumor-associated macrophages in osteosarcoma growth and metastasis via the FAK pathway | ||
Cell Rep Prostate cancer cell-derived exosomal IL-8 fosters immune evasion by disturbing glucolipid metabolism of CD8+ T cell | ||
J Transl Med RBM15 recruits myeloid-derived suppressor cells via the m6A-IGF2BP3/CBR3-AS1/miR-409-3p/CXCL1 axis, facilitating radioresistance in non-small-cell lung cancer |